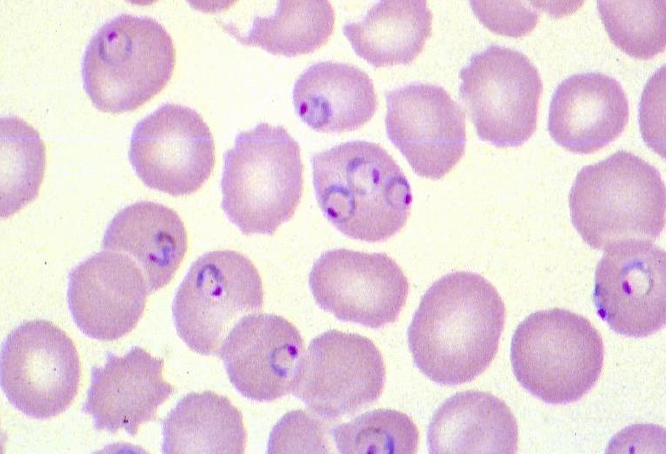
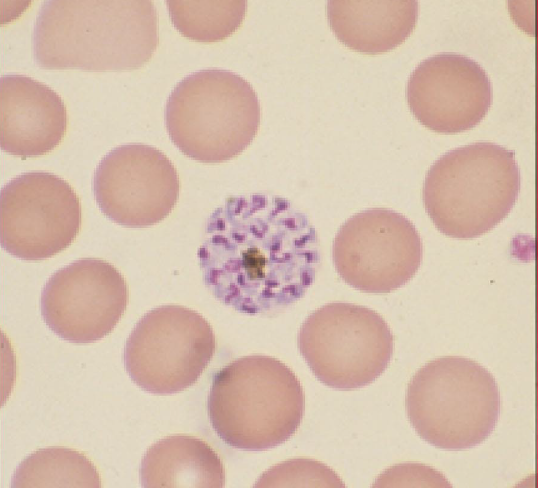
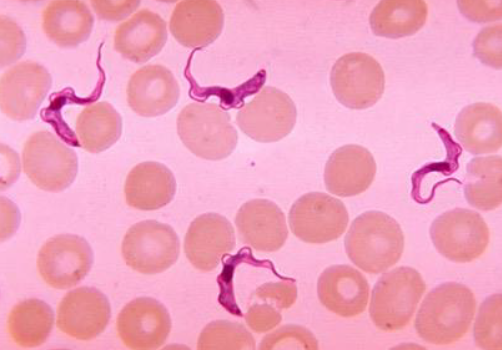

“lumpy jaw”, with lumps and sinus tracts after dental or jaw trauma.= ? Rx
Actinimycosis
Penicillin
Tubo-ovarian abscess, complication of intrauterine device (IUD), =
Actinomycosis
Penicillin rx
Hx : insidious onset lethargy, mild mucohemorrhagic diarrhea, non specific cramping & abdominal pain
Epi: lifelong freshwater exposure in endemic area of Africa
PE: diffuse abdominal tenderness, minimal hepatomegaly, mild malnutrition
Dx?
Rx?
Complication?
Schistosomiasis
Lab: S. mansoni ova in stool, mild eosinophilia, periportal fibrosis on U/S
Rx: Praziquantel
associated with bladder cancer
Hx: chronic cough with blood streaked sputum,
progressive chest discomfort, breathlessness on exertion
Epi: ingestion of raw freshwater crab in China, Japan, Korea, Taiwan, Philippines, India, Africa, South & Central America
Lab: CXR: patchy cystic infiltrate. Eosinophilia
Dx? Ix? Rx?
Paragonimus IgG (+).
Eggs of Paragonimus westermani in sputum or stools.
Rx: Praziquantel X 3 days
Hx: acute onset of fever, RUQ abdominal pain, anorexia, nausea, vomiting, dark urine, lasting weeks
Epi: ingestion of raw watercress, lettuce, or alfalfa
in cattle & sheep farm
PE: fever , jaundice , hepatomegaly
Dx? Ix? Rx?
Fasciola Hepatica
Fas2 ELISA (+), Fasciola
hepatica Western blot (+). ve stools
Triclabendazole for 2 days .
Hx evanescent pruritus, maculopapular rash often on trunk
Epi: West Africa, expat, back home for 1 year
PE: dermatitis, normal ocular exam, nodules rare
Lab: scanty microfilariae in skin snips
Dx? Rx?
Onchocerca volvulus
Ivermectin 12 months titrated to symptoms for up to 10 years.
Doxycycline X 6 weeks.
Hx Transient swellings, arthralgia, inconstant pruritus
Epi: expat, West or Central Africa
Eosinophilia
May migrate to?
Dx? Ix? Rx?

Loasis - ‘the eye worm’
[Calabar swellings]
antifilarial IgG (+), worm in Eye
Diethylcarbamazine X 3 wks
[So long as <2500mf/ml
Hx initial diarrhea & non specific abdominal complaints followed by fever, facial edema, painful swollen muscles including respiratory & mastication
Epi: worldwide, tropical & non tropical, ingestion of poorly cooked meat of any carnivorous animal, including pigs
PE: Temp 40 C. Tender swollen muscles, edema, chemosis, urticaria.
ESR=0, massive eosinophilia,
Dx? Ix? Rx?
Trichinella spiralis
T. spiralis IgG (+)
Deltoid muscle biopsy with larvae,
Albendazole & steroids
Hx 2 yo with fever, malaise, RUQ discomfort, anorexia, sleep disturbance
Epi: geophagia, exposure to dogs/cats,
PE: hepatomegaly, wheezing
Lab: Massive eosinophilia,
No eggs in stool.
Dx? Ix? Rx?
Visceral Lava migrans
Toxocara
T. canis IgG (+)
Albendazole. Consider steroids.
Hx severe intractable headache, nausea, mild neck stiffness, paresthesias
Epi: ingestion of raw snails/slugs alone, or green vegetables in Asia or Pacific region
Lab: Eosinophilia,
CSF: OP 50 cm, normal glucose, raised protein, Eosinophilic
=?
Rx?
Angiostrongylus cantonensis
Repeated lumbar puncture, analgesics, +/ steroids.
Hx fever, non specific abdominal symptoms, intermittent painless subcutaneous swellings
Epi: ingestion of undercooked chicken, fish, frog, reptile in Asia or Latin America
PE: Temp 38 C. Subcutaneous migratory swelling.
Lab: eosinophilia,
=?
Ix?
Rx?
Key comp?

Gnathostomiasis
ELISA for G. spinigerum
Albendazole X 3wk.
Intracerebral haemorrhage

Hx Non specific epigastric pain, intermittent diarrhea. Cough, wheezing diagnosis of allergies.
Epi: Resident or visitor to an endemic area of
Latin America USA, or SE Asia.
PE: Asymptomatic or may have non specific abdominal findings. Occasional rash pictured called?
Dx?
Ix?
Rx?

Larva currens
Simple Intestinal Strongyloidiasis stercoralis
stool strongy visualised.
Baermann or agar plate culture or sampling of upper GI secretions
Ivermectin.
Hx Corticosteroid or other immunosuppressive treatment. Non specific epigastric pain, intermittent diarrhea.
Epi: resident of an endemic area of Latin America, USA, or SE Asia
PE: Non specific abdominal findings. Ileus . : pneumonia, bacterial septicaemia , shock, no eosinophilia
Dx?
Key causes?
Rx?

Strongyloides hyperinfection
Steroids, HTLV-1, Cancer Rx
Ivermectin + antibiotics for bacterial infection
Hx: subacute febrile illness, right upper quadrant abdominal pain, weight loss
Epi: immigrants or residents in endemic areas of Asia, Africa & Latin America
PE: fever, pallor, exquisite point tenderness over the liver, dullness & rales at the right lung base
Lab/Xray: anemia, raised neutrophil WBC , Raised Alk. P.
Dx?
Ix? Seen on CXR?
Rx?

Amebiasis
E. histolytica IgG
US - Abscess right lobe liver .
CXR: elevated R diaphragm / effusion
Tinidazole + paromomycin
[Colitis on endoscopy - mimics IBD]

Hx: Fever, chills, muscle aches For 2 days. Fever constant.
Epi: One week volunteer work in rural area of Amazonian Brazil.
Blood film … no schizonts
Rx?
P. falciparum
Atovaquone proguanil 4 tabs qd X 3 or
ACT ( eg . Artemether lumefantrine bid X 3 days ),
Hx Travel to India 6 months earlier, took appropriate prophylaxis with atovaquone/proguanil. Acute onset of fever, chills/rigors, myalgias & headache
Epi: Traveler & endemic populations, worldwide distribution in tropics & subtropics, especially in India, the Americas, & SE Asia
PE: acutely ill & febrile, otherwise unremarkable Splenomegaly after a few days of illness
Lab: Anemia, leucopenia, thrombocytopenia.
Blood film….
Rx? When would you use alternative?
P Vivax relapse
Chloroquine
+ primaquine X 14d or Tafenoquine 300 mg
[ Vivax in Papua New Guinea, Indonesia requires ACT + primaquine]
Or ACT
Hx 21 yo with syncope , fatigue
Epi: childhood in rural Brazil , thatched roof dwelling
PE: Afebrile
Dx?
Seen on XR? Most common arrhythmia?
Ix?
Rx?
Trypanosoma cruzi
CXR: massive cardiomegaly
Complete RBBB
T. cruzi IgG (+). Xenodiagnosis
Rx Benznidazole , nifurtimox
[no benefit in late disease]
Acute systemic febrile illness in travelers; remembers painful tsetse bite in Tanzania
PE: high fever, inoculation chancre, rash, generalized lymphadenopathy
thrombocytopenia, anemia
Blood film shows:
Dx?
Essential Ix?
rx?
Trypanosoma brucei rhodesiense
CSF
Early disease -> Suramin
CNS infection -> Melarsoprol
Slow progressing neurological disease
PE: intermittent fever, posterior cervical lymph node, neurological signs
Dx?
Ix?
Rx?
Trypanosoma brucei gambiense
serological screening (CATT/RDT
LP - ALWAYS NEEDS AN LP
Early disease -> Pentamidine
CNS -> Eflornithine/nifurtimox
Fexinidazole for both early and CNS now
Hx: sudden unilateral loss of visual acuity without ocular pain
Epi: Ingestion of undercooked meat
PE: unilateral chorioretinitis, peri macular cotton wool spots
and no vascular involvement
Dx?
Key ix?
Rx?

Ocular toxoplasmosis - toxoplasma gondii
Toxoplasma IgG (+); IgM (+) in travelers
Pyrimethamine plus sulfadiazine and folinic acid 6 weeks
OR Co-trimoxazole
Hx: single painless chronic cutaneous ulcer progressing over weeks to months. Subsequent mucosal dissemination.
Epi: exposure in rainforested areas of S. America
PE: ulcer with raised indurated border with clean granulated base & with no surrounding inflammation
Which leish?
Leishmania V braziliensis
Pentavalent antimonals Eg SB5, AmphoB
Topical drug for limited cutnaeous leish?
topical paromomycin.
Imiquinoid
Hx febrile illness acute, subacute, or chronic course
Epi: Exposure to sandflies, zoonosis or anthroponosis rare in travelers, common in endemic populations. India, Sudan, Brazil, Southern Europe.
Exam: fever, cachexia, hepatosplenomegaly generalized lymphadenopathy
Pancytopenia with relative lymphocytosis, hypergammaglobulinemia, hypoalbuminemia.
Which type of leish?
Seen on labs?
Ix?
Rx?

L. donovani or
L.chagasi (=L. infantum)
Amastigotes in bone marrow or splenic aspirates.
Serology(+): DAT or rK39
Liposomal Amphotericin
[Miltefosine if oral]
Hx: abrupt onset fever, vomiting, diarrhea evolving to severe fatigue, anorexia, nausea, weight loss with intermittent diarrhea
Epi: Warm months in Nepal, Peru, Guatemala.
Dx?
Ix?
Rx?

Cyclospora cayetanensis.
Stool with AFB (+). 10um
Co-trimoxazole
































